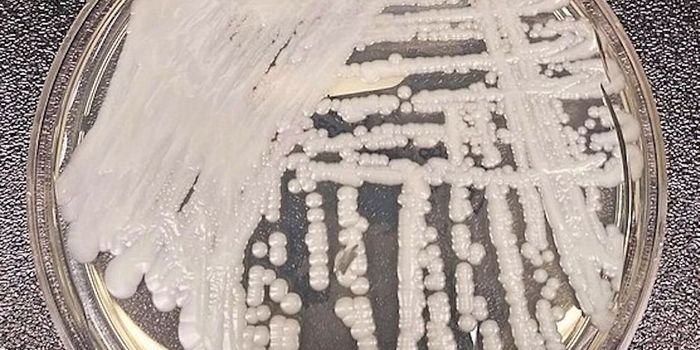
Is Climate Change to Blame for the Rise of Candida auris?

Disease surveillance
Disease surveillance is a methodology in where epidemiologists monitor the spread of a specific disease in order to understand how it progresses. The goals of disease surveillance are to predict, observe, and minimize the harm caused by diseases which present as outbreaks, epidemics, or pandemics.
-
MAR 05, 2020Health & MedicineColorectal cancer rates are rising among young Americans, according to the most recent report from the American Cancer S ...Written By: Tiffany DazetFEB 12, 2020MicrobiologyThough vaccination rates are high, small mumps outbreaks sometimes still occur.Written By: Carmen LeitchDEC 19, 2019Health & MedicineEven with a decade full of diet trends and superfoods, obesity rates in the United States continue to climb. According t ...Written By: Tiffany DazetDEC 15, 2019MicrobiologyThe fatality rate of Nipah virus has an estimated range of 40 to 75 percentWritten By: Carmen LeitchDEC 01, 2019CancerPeeing on a stick may not just be for pregnancy-detection anymore – an at-home urine test could also detect prosta ...Written By: Kathryn DeMuth SullivanNOV 29, 2019ImmunologyDestroying human cells compromised by viruses and cancer is the name of the game for so-called “killer” cell ...Written By: Kara MarkerNOV 18, 2019Cannabis SciencesResearch from two new preliminary studies presented at the American Heart Association’s (AHA) annual Scientific Se ...Written By: Kara MarkerNOV 10, 2019MicrobiologyFor the first time since 2000, researchers have identified a new subtype of HIV.Written By: Carmen LeitchOCT 17, 2019Health & MedicineLast week, the Centers for Disease Control and Prevention (CDC) released its annual Sexually Transmitted Disease Surveil ...Written By: Tiffany DazetSEP 20, 2019MicrobiologyAn international team of scientists has identified strains of extensively drug-resistant Salmonella typhimurium.Written By: Carmen LeitchSEP 08, 2019Health & MedicineAcute flaccid myelitis (AFM), a polio-like infection, caught the attention of physicians in the U.S. during late summer ...Written By: Dena ArutaAUG 17, 2019Genetics & GenomicsClostridium difficile is the primary cause of infections that are acquired in hospital settings; it causes diarrhea and ...Written By: Carmen LeitchAUG 13, 2019TechnologyArtificial intelligence (AI) is rapidly infiltrating all kinds of applications, helping even those located in remote are ...Written By: Nouran AminAUG 03, 2019Cell & Molecular BiologyAround 220 million people get malaria every year after being bitten by a mosquito infected with the parasite that causes ...Written By: Carmen LeitchJUL 24, 2019MicrobiologyIn recent years, the fungus Candida auris has emerged as a growing public health threat. The infection is usually seriou ...Written By: Carmen LeitchJUL 20, 2019Earth & The EnvironmentEver heard of huanglongbing? While more commonly referred to as citrus greening disease, huanglongbing (HLB) is threaten ...Written By: Kathryn DeMuth SullivanJUL 04, 2019Health & MedicineArboviruses are arthropod-borne pathogens with more than 130 strains known to cause human infections. The majority of th ...Written By: Dena ArutaMAY 30, 2019CancerA recent study from the National Cancer Institute (NCI) found uterine cancer rates among all women rose about 1 percent ...Written By: Julia TraversMAY 07, 2019Plants & AnimalsIf you didn’t already know, African swine fever (ASF) is currently ravaging large sums of pigs in the Eastern hemi ...Written By: Anthony BouchardAPR 21, 2019MicrobiologyAntibiotic-resistant infections cause the deaths of about 23,000 Americans every year. By 2050, they're projected to kil ...Written By: Carmen LeitchMAR 15, 2019Health & MedicineTick-borne diseases have significantly increased in the U.S. in the past few years. In 2016 there were 48,610 repor ...Written By: Dena ArutaMAR 03, 2019Health & MedicineChronic wasting disease (CWD) in deer and elk (cervids) has been rapidly spreading across North America and ha ...Written By: Dena ArutaFEB 10, 2019MicrobiologySome viruses, like Zika, can be challenging to study when they suddenly cause outbreaks because they can be very difficu ...Written By: Carmen LeitchFEB 08, 2019CardiologyIn the largest study of its kind, researchers examined data from the Behavioral Risk Factor Surveillance System (BRFSS). ...Written By: Abbie Arce
MAR 05, 2020
Health & Medicine
Colorectal cancer rates are rising among young Americans, according to the most recent report from the American Cancer S
...
Written By:
Tiffany Dazet
FEB 12, 2020
Microbiology
Though vaccination rates are high, small mumps outbreaks sometimes still occur.
Written By:
Carmen Leitch
DEC 19, 2019
Health & Medicine
Even with a decade full of diet trends and superfoods, obesity rates in the United States continue to climb. According t
...
Written By:
Tiffany Dazet
DEC 15, 2019
Microbiology
The fatality rate of Nipah virus has an estimated range of 40 to 75 percent
Written By:
Carmen Leitch
DEC 01, 2019
Cancer
Peeing on a stick may not just be for pregnancy-detection anymore – an at-home urine test could also detect prosta
...
Written By:
Kathryn DeMuth Sullivan
NOV 29, 2019
Immunology
Destroying human cells compromised by viruses and cancer is the name of the game for so-called “killer” cell
...
Written By:
Kara Marker
NOV 18, 2019
Cannabis Sciences
Research from two new preliminary studies presented at the American Heart Association’s (AHA) annual Scientific Se
...
Written By:
Kara Marker
NOV 10, 2019
Microbiology
For the first time since 2000, researchers have identified a new subtype of HIV.
Written By:
Carmen Leitch
OCT 17, 2019
Health & Medicine
Last week, the Centers for Disease Control and Prevention (CDC) released its annual Sexually Transmitted Disease Surveil
...
Written By:
Tiffany Dazet
SEP 20, 2019
Microbiology
An international team of scientists has identified strains of extensively drug-resistant Salmonella typhimurium.
Written By:
Carmen Leitch
SEP 08, 2019
Health & Medicine
Acute flaccid myelitis (AFM), a polio-like infection, caught the attention of physicians in the U.S. during late summer
...
Written By:
Dena Aruta
AUG 17, 2019
Genetics & Genomics
Clostridium difficile is the primary cause of infections that are acquired in hospital settings; it causes diarrhea and
...
Written By:
Carmen Leitch
AUG 13, 2019
Technology
Artificial intelligence (AI) is rapidly infiltrating all kinds of applications, helping even those located in remote are
...
Written By:
Nouran Amin
AUG 03, 2019
Cell & Molecular Biology
Around 220 million people get malaria every year after being bitten by a mosquito infected with the parasite that causes
...
Written By:
Carmen Leitch
JUL 24, 2019
Microbiology
In recent years, the fungus Candida auris has emerged as a growing public health threat. The infection is usually seriou
...
Written By:
Carmen Leitch
JUL 20, 2019
Earth & The Environment
Ever heard of huanglongbing? While more commonly referred to as citrus greening disease, huanglongbing (HLB) is threaten
...
Written By:
Kathryn DeMuth Sullivan
JUL 04, 2019
Health & Medicine
Arboviruses are arthropod-borne pathogens with more than 130 strains known to cause human infections. The majority of th
...
Written By:
Dena Aruta
MAY 30, 2019
Cancer
A recent study from the National Cancer Institute (NCI) found uterine cancer rates among all women rose about 1 percent
...
Written By:
Julia Travers
MAY 07, 2019
Plants & Animals
If you didn’t already know, African swine fever (ASF) is currently ravaging large sums of pigs in the Eastern hemi
...
Written By:
Anthony Bouchard
APR 21, 2019
Microbiology
Antibiotic-resistant infections cause the deaths of about 23,000 Americans every year. By 2050, they're projected to kil
...
Written By:
Carmen Leitch
MAR 15, 2019
Health & Medicine
Tick-borne diseases have significantly increased in the U.S. in the past few years. In 2016 there were 48,610 repor
...
Written By:
Dena Aruta
MAR 03, 2019
Health & Medicine
Chronic wasting disease (CWD) in deer and elk (cervids) has been rapidly spreading across North America and ha
...
Written By:
Dena Aruta
FEB 10, 2019
Microbiology
Some viruses, like Zika, can be challenging to study when they suddenly cause outbreaks because they can be very difficu
...
Written By:
Carmen Leitch
FEB 08, 2019
Cardiology
In the largest study of its kind, researchers examined data from the Behavioral Risk Factor Surveillance System (BRFSS).
...
Written By:
Abbie Arce